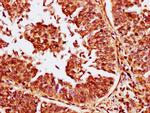
CABIN1 Antibody in Immunohistochemistry (Paraffin) (IHC (P))
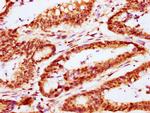
CABIN1 Antibody in Immunohistochemistry (Paraffin) (IHC (P))

Search
Invitrogen
CABIN1 Polyclonal Antibody
{{$productOrderCtrl.translations['antibody.pdp.commerceCard.promotion.promotions']}}
{{$productOrderCtrl.translations['antibody.pdp.commerceCard.promotion.viewpromo']}}
{{$productOrderCtrl.translations['antibody.pdp.commerceCard.promotion.promocode']}}: {{promo.promoCode}} {{promo.promoTitle}} {{promo.promoDescription}}. {{$productOrderCtrl.translations['antibody.pdp.commerceCard.promotion.learnmore']}}
图: 1 / 4
CABIN1 Antibody (PA5-98337) in IHC (P)

Please note: We are reviewing Western blot images included in the antibody testing data in our catalog, including those provided by third parties. Unless expressly labeled or annotated as “raw-unedited”, Western blot images included in the antibody testing data in our catalog may have been edited, optimized or otherwise adjusted for presentation.
产品信息
PA5-98337
种属反应
宿主/亚型
分类
类型
抗原
偶联物
形式
浓度
规格
纯化类型
保存液
内含物
保存条件
运输条件
RRID
靶标信息
Calcineurin binding protein (Cabin-1) and the corresponding rat homolog, designated Cain, are widely expressed nuclear phosphoproteins that regulate the serine/threonine phosphotase activity of calcineurin and influence T cell signaling and apoptosis. Calcineurin is required for the transcriptional activation of cytokines and the activation of various transcription factors, including NFAT, NFκB and AP-1, involved in T cell receptor (TCR)-mediated signaling. The regulation of calcineurin depends on the changes in intracellular calcium concentrations and the activity of protein kinase C. TCR activation results in PKC inducing the hyperphosphorylation of Cabin-1, which facilitates the high affinity binding of Cabin-1 to calcineurin. This complex formation, in turn, inhibits calcineurin activity and attenuates TCR-mediated signaling. Cabin-1 also associates directly with MEF-2 proteins, a family of transcription factors that regulate apoptosis signaling in T cells. This association between Cabin-1 and MEF-2 leads to the inhibition of MEF-2-mediated gene transcription and the inhibition of apoptosis.
仅用于科研。不用于诊断过程。未经明确授权不得转售。
篇参考文献 (0)
生物信息学
蛋白别名: CAIN; Calcineurin inhibitor; Calcineurin-binding protein cabin-1
基因别名: Cabin1; Cain
UniProt ID: (Rat) O88480
Entrez Gene ID: (Rat) 94165




